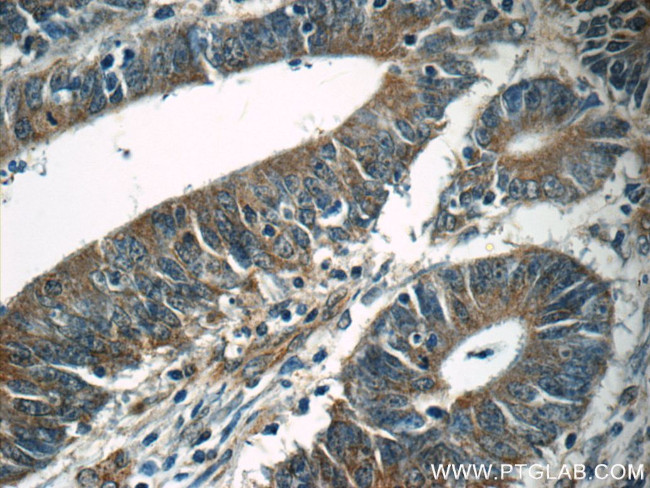
TPM3 Antibody in Immunohistochemistry (Paraffin) (IHC (P))
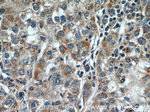
TPM3 Antibody in Immunohistochemistry (Paraffin) (IHC (P))

Search
Proteintech
TPM3 Polyclonal Antibody
{{$productOrderCtrl.translations['antibody.pdp.commerceCard.promotion.promotions']}}
{{$productOrderCtrl.translations['antibody.pdp.commerceCard.promotion.viewpromo']}}
{{$productOrderCtrl.translations['antibody.pdp.commerceCard.promotion.promocode']}}: {{promo.promoCode}} {{promo.promoTitle}} {{promo.promoDescription}}. {{$productOrderCtrl.translations['antibody.pdp.commerceCard.promotion.learnmore']}}
产品信息
55444-1-AP
种属反应
宿主/亚型
分类
类型
抗原
偶联物
形式
浓度
规格
纯化类型
保存液
内含物
保存条件
运输条件
靶标信息
TPM3 (tropomyosin 3) is a member of the tropomyosin family of actin-binding proteins involved in the contractile system of striated and smooth muscles and the cytoskeleton of non-muscle cells. Tropomyosins are dimers of coiled-coil proteins that polymerize end-to-end along the major groove in most actin filaments. They provide stability to the filaments and regulate access of other actin-binding proteins. In muscle cells, they regulate muscle contraction by controlling the binding of myosin heads to the actin filament. Mutations in this gene result in autosomal dominant nemaline myopathy, and oncogenes formed by chromosomal translocations involving this locus are associated with cancer. Multiple transcript variants encoding different isoforms have been found for this gene.
仅用于科研。不用于诊断过程。未经明确授权不得转售。
篇参考文献 (0)
生物信息学
蛋白别名: alpha-tropomyosin, slow skeletal; cytoskeletal tropomyosin isoform; cytoskeletal tropomyosin TM30; epididymis luminal protein 189; epididymis secretory sperm binding protein Li 82p; Gamma-tropomyosin; heat-stable cytoskeletal protein 30 kDa; high-molecular weight tropomyosin 3 protein; function unknown; hTM5; skalphaTM.2; tropomyosin; tropomyosin 3 nu; tropomyosin 5; Tropomyosin alpha-3 chain; tropomyosin gamma; Tropomyosin-3; Tropomyosin-5; unnamed protein product
基因别名: CAPM1; CFTD; CMYO4A; CMYO4B; CMYP4A; CMYP4B; gamma-TM; HEL-189; HEL-S-82p; hscp30; hTM30nm; hTMnm; NEM1; OK/SW-cl.5; TM-5; TM3; TM30; TM30nm; TM5; Tm5NM; TMnm; Tpm-5; TPM3; TPM3nu; Tpm5; TPMsk3; TRK; Trop-5
UniProt ID: (Human) P06753, (Mouse) P21107
Entrez Gene ID: (Human) 7170, (Mouse) 59069